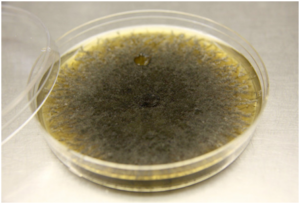

СКАЧАТЬ: МП Опасная плесень дома
Плесень — визуально различимый налет, который образуется в результате жизнедеятельности микроскопических грибов. Плесень производит споры, которые распространяются в воздухе. Невозможно предотвратить появление спор, они есть везде, мы приносим их домой на одежде и других вещах. Для разрастания грибка эти споры должны попасть в благоприятную среду - влажную и тёплую. Наиболее оптимальная температура для его развития +20°C, влажность 90% и более.
Грибок не сразу покрывает поверхности квартиры; на начальных этапах его можно определить по специфическому запаху сырости. И тогда же стоит потратить время на обнаружение источника. Чем скорее вы избавитесь от плесени, тем меньше у нее шансов размножиться, захватив новые области квартиры. Помимо эстетических неудобств и порчи вещей, она может быть опасна для здоровья: споры грибов настолько малы, что легко попадают в организм через легкие при вдыхании, а затем вырабатывают токсины.
Грибок может стать причиной многих заболеваний, таких как бронхиальная астма, кожные высыпания, пневмония, синусит, расстройства желудочно-кишечного тракта, носовые кровотечения, головные боли. Особенно опасна плесень для здоровья людей с аллергией.
Аллергия на плесень может проявляться аналогичными симптомами сезонной аллергии: заложенность носа, насморк,зуд в носу, першение в горле, чихание,резь в глазах и слезотечение. Люди с аллергией на плесень, а также с астмой всегда имеют более высокий риск развития приступа астмы, если в окружающей среде есть плесень.
Некоторые виды плесени, такие как Aspergillus, могут вызвать серьезные проблемы со здоровьем. Большинство людей вдыхают споры этого грибка, не заболевая, но люди с ослабленной иммунной системой или с заболеваниями легких могут иметь тяжелое течение аспергиллеза.
Видов грибков очень много, но есть те, которые чаще всего встречаются в жилых помещениях.
Черная плесень
Aspergillius Niger наиболее опасен. Он может прорастать не только на обоях, но и на окрашенных бетонных стенах и кафеле в ванной комнате. Чаще всего это происходит из-за органических загрязнений, которые служат питательной средой. Существует пищевая черная плесень — заметный налет на испорченных продуктах, их строго необходимо выбрасывать.
Зеленая плесень
Не менее распространенный вид, который встречается в квартирах и домах. Обычно это грибы вида Penicillium. Они похожи на мох, отличаются насыщенно-зеленым цветом и имеют неровную поверхность. Зеленая плесень поражает продукты питания и пористые поверхности, включая стены, мебель и потолки.
Розовая плесень
Один из немногих видов грибка, от которого несложно избавиться. Мицелий не углубляется в структуру материала, развиваясь на его поверхности. Поэтому в борьбе с розовой плесенью иногда бывает достаточно качественной уборки.
Белая плесень
Грибок вида Mucor проявляется в виде светлого налета в цветочных горшках. Это происходит из-за обильного полива в теплом помещении. Если плесень появилась, наилучшим решением будет пересадить растение, удалив все пораженные части почвы.
Синяя плесень
Грибок Ceratocystis серо-синего цвета растет на деревянных поверхностях. Он поражает паркетные полы и мебель, портит их внешний вид и постепенно разрушает. Не путайте этот вид с голубой плесенью. Последняя не опасна для организма и используется в производстве сыров.
Как избавиться от плесени
Существует множество народных и профессиональных средств, эффективных для удаления различных видов плесени. Но все они будут иметь временный эффект, если не устранить первопричину — условия, подходящие для развития грибка.
Перекись водорода
Противогрибковый и антибактериальный раствор, который есть во многих аптечках, — хорошее средство от плесени. Налейте в распылитель перекись водорода с концентрацией 3%. Его можно использовать на кухонной технике, столешницах, ванне, твердых полах и поверхностях стен. Сначала проверьте незаметный участок, чтобы предотвратить обесцвечивание или повреждение. Пропитайте заплесневелую поверхность жидкостью и оставьте на десять минут. Затем потрите область с усилием, достаточным для удаления пятен, и вытрите насухо.
- Эфирные масла
Многие эфирные масла используются не только для ароматерапии. Эссенции обладают антисептическими и дезодорирующими свойствами, отпугивают насекомых и помогают избавиться от плесени. Масло чайного дерева, розмарина и лаванды — натуральные фунгициды, который быстро очищают грибковые споры и предотвращают их повторное появление.
Смешайте одну чайную ложку масла чайного дерева с 200 мл чистой воды, хорошо взболтайте в закрытой емкости. Распылите средство на заплесневелый участок, оставьте высыхать на час. Затем протрите поверхность сухим полотенцем или тряпкой из микрофибры. Некоторые эфирные масла раздражают кожу, поэтому рекомендуется использовать перчатки.
- Белый уксус
Слабокислый пищевой продукт очищает и дезинфицирует. Уксус безопасен для большинства поверхностей, а специфический запах быстро выветривается. Он может убить 82% видов плесени, включая сложную черную. Лучше использовать неразбавленную кислоту, так повышается ее эффективность. Налейте белый уксус в пульверизатор, распылите на заплесневелую поверхность и оставьте на час. Протрите участок чистой водой и дайте ему высохнуть. Уксус испарится в течение пары часов и запах исчезнет.
- Лимоны
Лимон может быть антисептиком, отбеливателем, пятновыводителем и очистителем. Этот фрукт поможет удалить черную плесень. Высокая концентрация кислоты в лимонах разрушает мицелий, помогает легко удалить налет и дезинфицирует поверхность.
Выдавите сок трех — пяти лимонов в чашку и нанесите его на заплесневелый участок. Оставьте на пять минут, а затем протрите поверхность влажным полотенцем. Смесь можно наносить повторно для наилучшего очищения и не смывать ее.
- Пищевая сода
У соды множество преимуществ в бытовом использовании, это отличное чистящее и дезинфицирующее средство. Она безопасна для детей и домашних животных, поэтому нередко входит в состав профессиональных средств для уборки. Помимо удаления плесени, сода отлично впитывает запахи и влагу.
Смешайте половину столовой ложки соды с 0,5 л воды и взболтайте в пульверизаторе. Распылите состав на пораженные плесенью участки, удалите налет щеткой и ополосните водой. После этого снова нанесите содовый раствор и оставьте высыхать. Этот способ позволяет уничтожить оставшуюся плесень и предотвратит появление новой.
- Отбеливатель
Средство подходит для гладких поверхностей — стекол и плитки. Отбеливатель типа «Белизна» нужно смешать с водой в пропорции 1 к 10. Нанесите на поверхности с помощью кисти, оставьте на час, после чего промойте чистой водой. Не стоит использовать его для стен с обоями или краской, мебели и пола — возможно удаление верхнего слоя и обесцвечивание поверхностей.
- Нашатырный спирт
Действие средства аналогично эффекту от отбеливателя. Нашатырный спирт подходит для гладких, непористых поверхностей. Смешайте его в пропорции 1:1 с водой и распылите на зараженный участок. Будьте осторожны: едкий запах нашатыря может стать причиной головокружения. Не комбинируйте спирт с отбеливателем — химическая реакция приводит к выделению токсичных газов.
-
Бура
Натриевая соль борной кислоты — природное средство, которое применяют для дезинфекции. Это эффективный фунгицид и инсектицид, который токсичен для грибка. Перед применением раствора буры, смешанной с водой в пропорции 1:10, пропылесосьте поверхности. Нанесите средство жесткой щеткой и очистите налет. Смывать буру не нужно: высохший раствор обладает профилактическими свойствами, не позволяя новым грибницам прорасти на обработанных участках.
-
Раствор йода и камфорные шарики
Этот способ подходит только при недавно появившейся плесени, которая еще не успела закрепиться на стенах и мебели. В зараженном помещении расставляют емкости с раствором йода и раскладывают камфорные шарики. Их нужно оставить на несколько часов; вариант подходит для нежилых помещений или, например, старых квартир перед ремонтом.
- Антисептическая грунтовка
Проверенный способ с эффективным средством из строительного магазина. Перед нанесением грунтовки на зараженную поверхность постарайтесь максимально счистить с нее плесень. В случае глубокого прорастания мицелия со стен удаляют не только обои и краску, но также слои штукатурки вплоть до бетона и кирпича. Раствор продается как в готовом виде, так и для разведения водой.
Эффект любого метода обработки поверхностей от плесени будет носить временный характер. Необходимо устранить причины появления грибов и не создавать благоприятные условия для их развития. Если влажность воздуха превышает 60%, то квартиру надо осушать с помощью электроприборов, если ниже 35% — прибегнуть к помощи различных типов увлажнителей. Плесневые грибы — устойчивые микроорганизмы. По степени жизнеспособности самые слабые — бактерии, затем идут вирусы и замыкают этот ряд спорообразующие культуры. Поэтому, например, доза ультрафиолетового излучения (УФ), необходимая для уничтожения плесневых грибов, в десятки и сотни раз превышает таковую для бактерий или вирусов. Целесообразно использовать УФ-рециркуляторы, так как в процессе многократной рециркуляции грибы постепенно получают достаточную дозу и отмирают.
По мнению некоторых специалистов, наиболее эффективным методом борьбы с плесенью является использование антимикробных воздушных фильтров, обеспечивающих высокую степень очистки от микроорганизмов и пыли. Это актуально для лечебных учреждений, где к качеству воздуха предъявляются повышенные требования. В зданиях аптек и лечебных учреждений — больниц, (кроме инфекционных), поликлиник и т. п. — должна быть приточно-вытяжная вентиляция с механическим побуждением. В любом помещении необходимо соблюдать режим проветривания: форточки и фрамуги рекомендуется открывать часто, но на короткое время.
Все работы по уничтожению плесени необходимо проводить в перчатках и используя защиту органов дыхания — респираторы. Чтобы уничтожить уже появившиеся плесневые грибы с поверхностей, рекомендован ряд дезинфицирующих средств, обладающих фунгицидными (противогрибковыми) свойствами. Все они подлежат государственной регистрации и имеют комплект документов, в том числе утвержденную инструкцию по применению, сертификаты и декларацию о безопасности.
Совместно с обработкой помещения от плесени проводятся профилактические инсектицидные меры для предотвращения разноса спор на лапках вредителей. При проведении профессиональной обработки нужно покинуть жилье, после нее — проветрить. В помещении можно находиться после полного высыхания обработанных поверхностей.
Чтобы избежать развития грибка в доме и его влияния на здоровье, необходимо:
- реже находиться сырых и плохо проветриваемых помещениях;
- регулировать влажность и температуру воздуха;
своевременно избавляться от предметов, пораженных плесенью, чтобы она не распространялась на другие участки; - регулярно проводить влажную уборку;
- не допускать протекание сантехники, вовремя устранять протечки;
держать открытой дверь в ванную комнату, шторку расправлять до полного высыхания; - не закрывать внутридомовые вентиляционные ходы в жилых помещениях;
- следить за комнатными растениями: не заливать их и вовремя пересаживать;
- выбрасывать испорченные продукты;
- не допускать объединение вентиляционных каналов кухонь и санитарных узлов с жилыми комнатами.
Для отделки жилых помещений лучше использовать натуральные дышащие материалы с хорошей воздухопроницаемостью. При проведении строительных и ремонтных работ необходимо пользоваться защитной одеждой, масками и респираторами, защитными очками, перчатками. В случае попадания плесени в организм, если замечаете у себя побочные реакции, обязательно обращайтесь к врачу. Будьте здоровы!